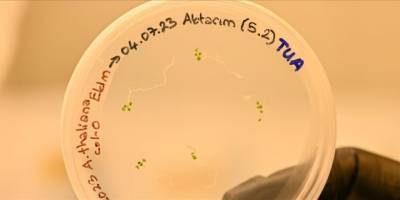
Türk bilim insanları uzayda bitki yetiştirecek

- YILLAR SONRA BİR İ̇LK: SATÜRN’ÜN HALKALARI KAYBOLUYOR
![Yıllar sonra bir i̇lk: Satürn’ün halkaları kayboluyor]()
- MARS'TAN GELEN BÜYÜK SİNYAL, BİLİM DÜNYASI ŞOKTA: KIZIL GEZEGEN’DE AKIL ALMAZ BİR İZ BULDU
![Mars'tan gelen büyük sinyal, bilim dünyası şokta: Kızıl Gezegen’de akıl almaz bir iz buldu]()
![Türkiye Uzay Ajansı uluslararası faaliyetlerinde şirketleşebilecek]()
![Türkiye uyduda küresel markalar çıkarmak için düğmeye bastı]()
![Meta’dan yeni rezalet: 'iPhone'lardaki tüm verilere ulaşmaya çalışıyor’]()
- ÇİN, PIESAT-2 UYDULARINI FIRLATTI
![Çin, PIESAT-2 uydularını fırlattı]()
- LABORATUVARDA 'YAPAY ALTIN' ÜRETİLDİ, EN YAYGIN YATIRIM ARACININ DEĞERİ DÜŞECEK Mİ?
![Laboratuvarda 'yapay altın' üretildi, en yaygın yatırım aracının değeri düşecek mi?]()
![İş Bankasının "Yapay Zeka Fabrikası Ödülleri" sahiplerini buldu]()
![Yeni Excalibur 27 inç Curved Gaming monitör satışa çıktı]()
- SADECE TOROSLAR'DA YETİŞİYOR: 'BU KEŞFİN ÇÖZMEDİĞİ HASTALIK YOK'
![Sadece Toroslar'da yetişiyor: 'Bu keşfin çözmediği hastalık yok']()
![Kaspersky AIM Global'a katıldı]()
- ABD'DE BİDEN YÖNETİMİ, ÇİP SEKTÖRÜNDE ÇİN'E YENİ KISITLAMALAR GETİRDİ
![ABD'de Biden yönetimi, çip sektöründe Çin'e yeni kısıtlamalar getirdi]()
![Kamuda yapay zeka ekosistemini güçlendirmek için çağrıya çıkıldı]()
![Togg yolu açtı, yerli kamerada hedef "unicorn"]()
- BAYRAKTAR TB3, TCG ANADOLU'YA İKİ KEZ DAHA BAŞARIYLA İNİŞ KALKIŞ GERÇEKLEŞTİRDİ
![Bayraktar TB3, TCG Anadolu'ya iki kez daha başarıyla iniş kalkış gerçekleştirdi]()
- YAPAY ZEKA ÇAĞI BAŞLADI: KONTROL KİMDE OLACAK?
![Yapay zeka çağı başladı: Kontrol kimde olacak?]()
![HÜRJET'in ikinci prototipi yeni boyasıyla gökyüzüne havalandı]()
![Kaspersky, perakende odaklı siber tehditlerde artış tespit etti]()
![Bayraktar TB3, TCG Anadolu'ya ilk kalkış ve inişini başarıyla tamamladı]()
- YAPAY ZEKA DESTEKLİ SİSTEMLERLE YOL GÜVENLİĞİNİ ARTIRMAK MÜMKÜN
![Yapay zeka destekli sistemlerle yol güvenliğini artırmak mümkün]()